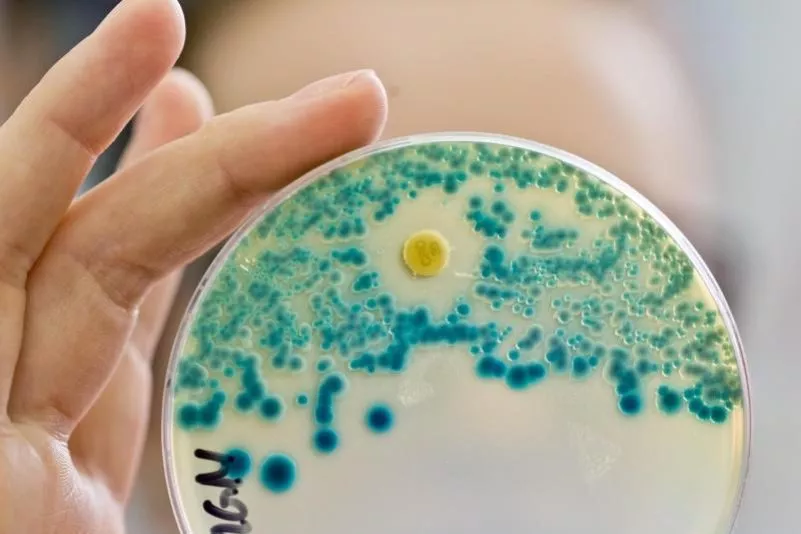
top-article-image

Viele Klinikpatienten bringen multiresistente Keime mit
Viele Krankenhauspatienten bringen einer neuen Studie zufolge bereits von zu Hause multiresistente Keime mit in die Kliniken. Mindestens 9,5 Prozent seien bei ihrer Ankunft mit den Bakterien besiedelt, gegen die gängige Antibiotika nichts machen können. Die Strategie, Betroffene zu isolieren, funktioniert nicht mehr, man könne nicht zehn Prozent der Patienten in Isolation stecken.
Nachweis von multiresistenten Bakterien: Viele Krankenhauspatienten bringen bereits von zu Hause die tödlichen Keime mit in die Kliniken.
Foto: Daniel Karmann/Archiv/dpa
Viele Krankenhauspatienten bringen einer neuen Studie zufolge bereits von zu Hause multiresistente Keime mit in die Kliniken.
Mindestens 9,5 Prozent seien bei ihrer Ankunft mit den Bakterien besiedelt, gegen die gängige Antibiotika nichts machen können, sagte der Forscher Axel Hamprecht von der Uniklinik Köln am Montag. Diese Größenordnung habe man so nicht erwartet.
Für die Studie wurden mehr als 4000 Erwachsene bei ihrer Klinikaufnahme mit Stuhlproben und Rektalabstrichen untersucht. Besonderes Augenmerk sei dabei auf 3GCREB-Keime gelegt worden – multiresistente Darmbakterien. Im Ergebnis hätten von 4376 Erwachsenen 416 diese Keime getragen, also fast jeder zehnte. An der Studie hatten sich sechs deutsche Universitätskliniken beteiligt.
Das Gros der Keime, die in Krankenhäusern für Infektionen sorgen, sind normalerweise harmlose Bakterien, mit denen viele Menschen besiedelt sind. Bleiben sie, wo sie hingehören, gibt es keine Probleme. Geraten sie aber in Blutbahn, Blase oder Lunge, können sie zur Gefahr werden. Sehr problematisch sind dabei die multiresistenten Keime. Gängige Antibiotika schlagen bei ihnen nicht mehr an. Die Therapie wird dadurch schwieriger.
Die in der Studie untersuchten Bakterien sind dabei nur eine Gruppe unter mehreren. Wolle man das Gesamtphänomen der von Patienten in Kliniken eingeschleppten Bakterien beschreiben, kommen andere Keime Hamprecht zufolge auf die errechneten 9,5 Prozent noch oben drauf – etwa der bekannte MRSA-Erreger. „Die werden aber nicht diese Menge ausmachen“, sagte er.
Angesichts der Ergebnisse sprechen sich die Studienautoren unter anderem für bessere Hygienemaßnahmen in den Kliniken und für weniger nicht gerechtfertigten Antibiotika-Einsatz aus. Resistente Erreger entstehen vermutlich unter anderem, weil Antibiotika in der Tiermast, aber auch bei Menschen zu häufig und nicht zielgenau verabreicht werden.
Die Strategie, Betroffene zu isolieren, funktioniere hingegen nicht mehr, sagte Hamprecht. Man könne nicht zehn Prozent der Patienten in Isolation stecken. Im Fall der untersuchten Darmbakterien könne man zudem eigentlich nur abwarten. „Wir haben da keine Möglichkeit, den Patienten etwas zu geben, damit sie sie wieder los werden.“ Das unterscheide sie etwa von MRSA. (dpa)
Kommentare
Noch keine Kommentare – schreiben Sie den ersten Kommentar zu diesem Artikel.
0
Kommentare
Noch keine Kommentare – schreiben Sie den ersten Kommentar zu diesem Artikel.





